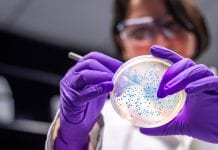
New Oxford University institute to fight antimicrobial resistance New Oxford University institute to fight antimicrobial resistance
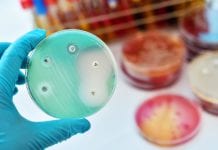
New way to increase antimicrobial sensitivity discovered New way to increase antimicrobial sensitivity discovered

Antimicrobial Resistance Related News
New antimicrobial nanotech could prevent and treat superbugs
A new nanothin antibacterial coating has been developed that could help prevent and treat deadly superbugs.
A team of researchers led by RMIT University in...
Antimicrobial resistance prevention, research, and policy
Professor Jan-Ingvar Jönsson, Chair of the Joint Programming Initiative on Antimicrobial Resistance, tells HEQ about the burden and prevention of AMR.
The Joint Programming Initiative...
Tackling drug-resistant infections: from evidence to action
Dr Ghada Zoubiane and Georgiana-Simona Baciu of the International Centre for AMR Solutions explore the risks posed by antimicrobial resistance, as well as how to tackle drug-resistant infections.
COVID-19 and the fight against antimicrobial resistance
Arlene Brailey, Patient Support Officer at Antibiotic Research UK, discusses the burden of antimicrobial resistance, COVID-19 and the need for targeted research.
Health Europa Quarterly Issue 16
Welcome to Health Europa Quarterly issue 16, which explores the secondary issues adjacent to the COVID-19 pandemic, from the welfare and wellbeing of doctors...
Investigating bacteria behind hospital infections with SMART Designs Tool
A new tool has been developed using SMART CRISPRi technology which is designed to help identify and tackle causes of E. faecalis-related diseases and...
New Oxford University institute to fight antimicrobial resistance
A £100m donation from Ineos will create a new state of the art institute for antimicrobial research.
The world leading Ineos Oxford Institute (IOI) will...
Fast-tracking the use of copper in the NHS to tackle AMR
Rory Donnelly, clinical research director of Copper Clothing, discusses the need to fast track copper for use in the NHS as an antimicrobial material...
Could soil used in ancient Irish folk medicine fight antimicrobial resistance?
In a new discovery, a team of scientists have shown that Northern Irish soil has antibiotic-producing bacteria that could help in the fight against...
Fighting the AMR paradoxes in the age of COVID-19
Mariano Votta, Director of the Active Citizenship Network/Cittadinanzattiva, and Neda Milevska-Kostova, Vice Chair of the International Alliance of Patients Organisations, discuss the threat of...
Dealing with antimicrobial resistance during COVID-19
To coincide with Antimicrobial Awareness Week 2020, a new report of case studies has been published that gives a platform to people living with...
Global leaders advocate urgent action on antimicrobial resistance
As the antimicrobial resistance crisis accelerates across the globe, world leaders are advocating for urgent action to combat the problem.
The leaders, including the heads...
Hospital bacteria source highlights need for improved infection control
Findings from a new study have shown an under-recognised bacteria source – the hospital floor – that highlights the need for improved infection control...
Reducing antimicrobial resistance with copper
Antimicrobial resistance is a growing issue across the globe, and one company is addressing its burden on healthcare through the innovative use of copper.
The...
MEPs call for Pharmaceutical Strategy to tackle antimicrobial resistance
MEPs have called on the European Commission to tackle antimicrobial resistance (AMR) through the new Pharmaceutical Strategy for Europe.
The European Commission’s Pharmaceutical Strategy for...
COVID-19 antibody testing ‘the only safe pathway’
UK company Testing For All has launched a large scale finger-prick COVID-19 antibody testing kit aimed at providing accessibility and affordability for UK workers.
Testing...
Could COVID-19 lead to an increase in antimicrobial resistance?
According to a new study, the use of antibiotics in the treatment of COVID-19 could lead to an increase in antimicrobial resistance (AMR) among...
New way to increase antimicrobial sensitivity discovered
Scientists have discovered a new way to make bacteria more sensitive to antibiotics in a bid to tackle the antibiotic resistance crisis.
In a new...
Reducing wound bioburden with antimicrobial dressings
HEQ examines the role of dressings with antimicrobial properties in treating and preventing wound infection.
The increased prevalence of antimicrobial dressings in wound care can...
Is COVID-19 PPE contributing to the spread of resistant pathogens?
Health Europa speaks to infection control expert, Dr Jennie Wilson, to discuss high standard infection prevention and control practices, and whether current practices could...